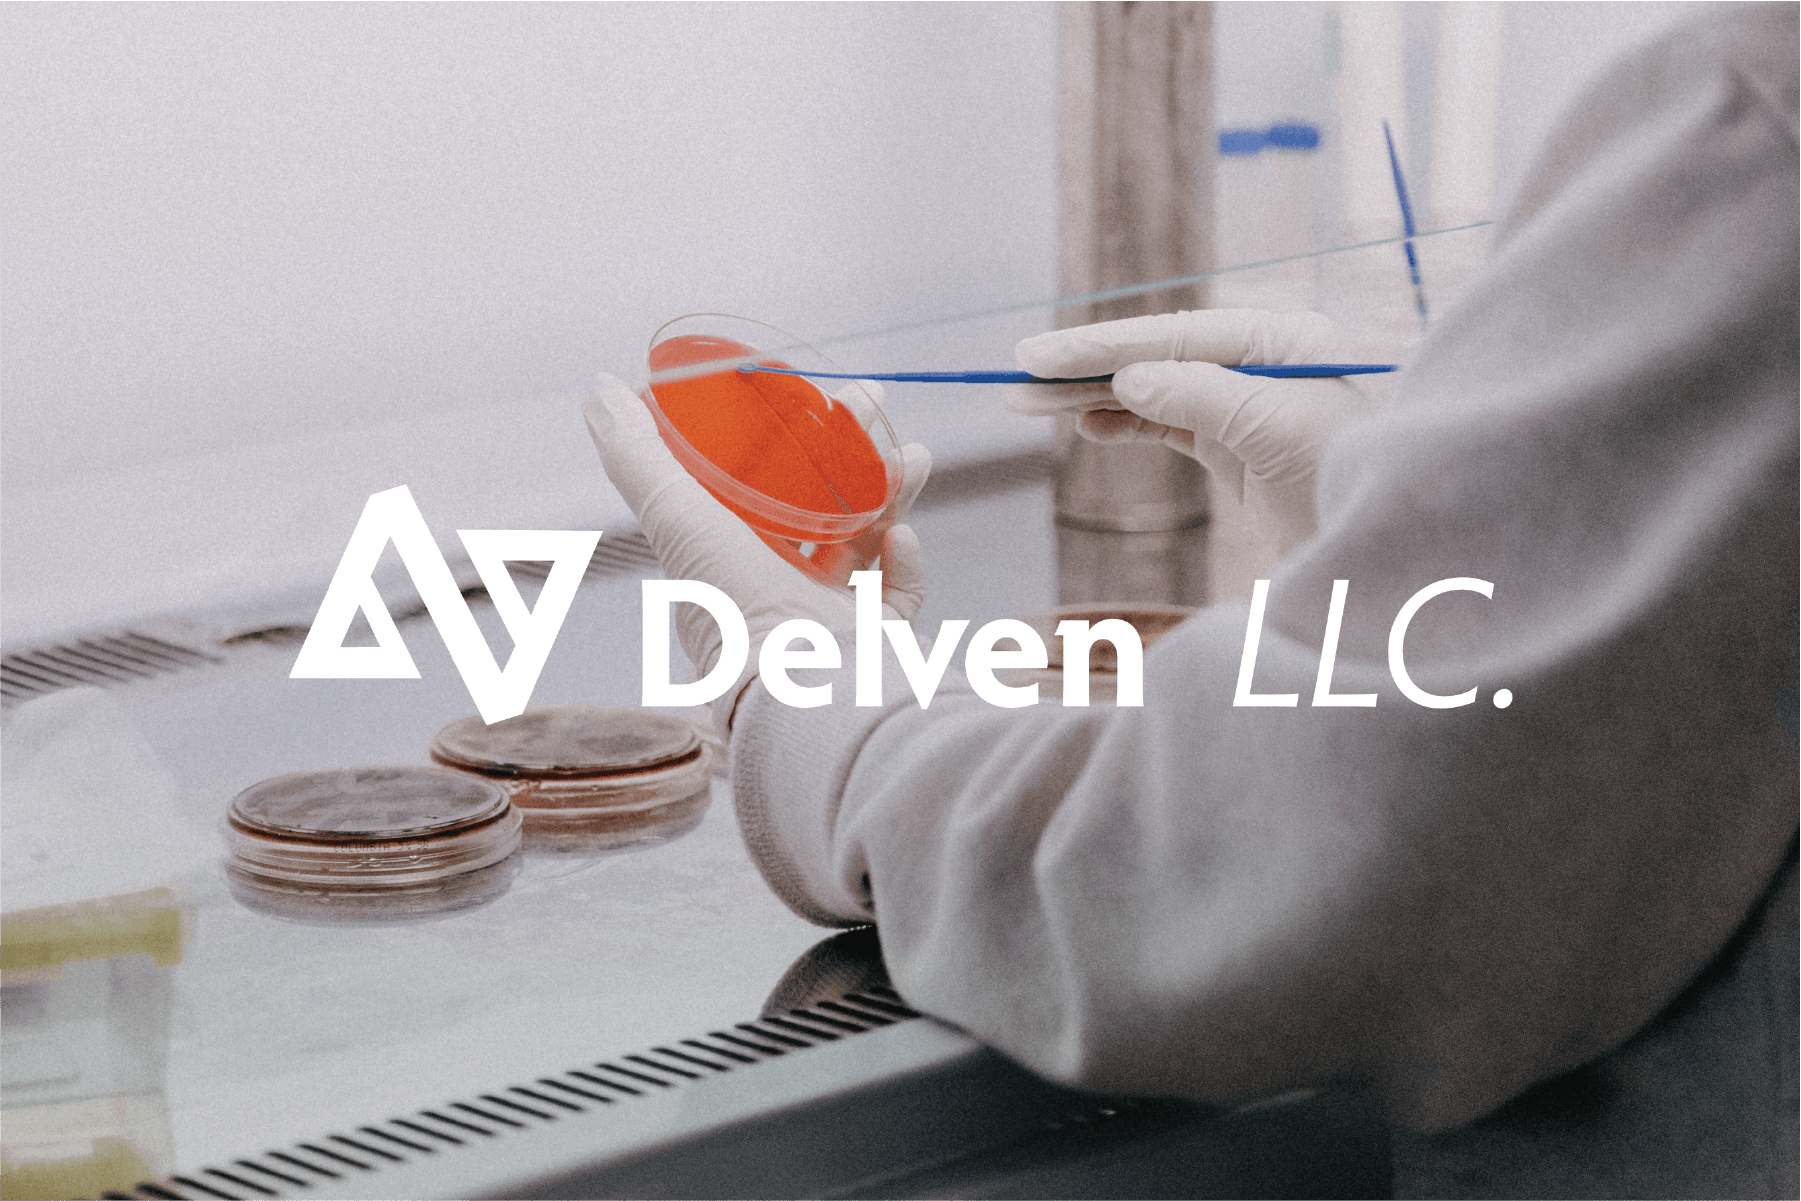

Delven
Brand Identity & Website Development
Delven Is a startup aimed at bridging the gap between researchers and study participants. Delven is a web platform designed to create higher quality scientific research. Participants can filter through studies and find one that matches their abilities and are guided through the research process in a clear concise way. This is a current project and will eventually include an entire ux designed web platform, icons, and illustrations.